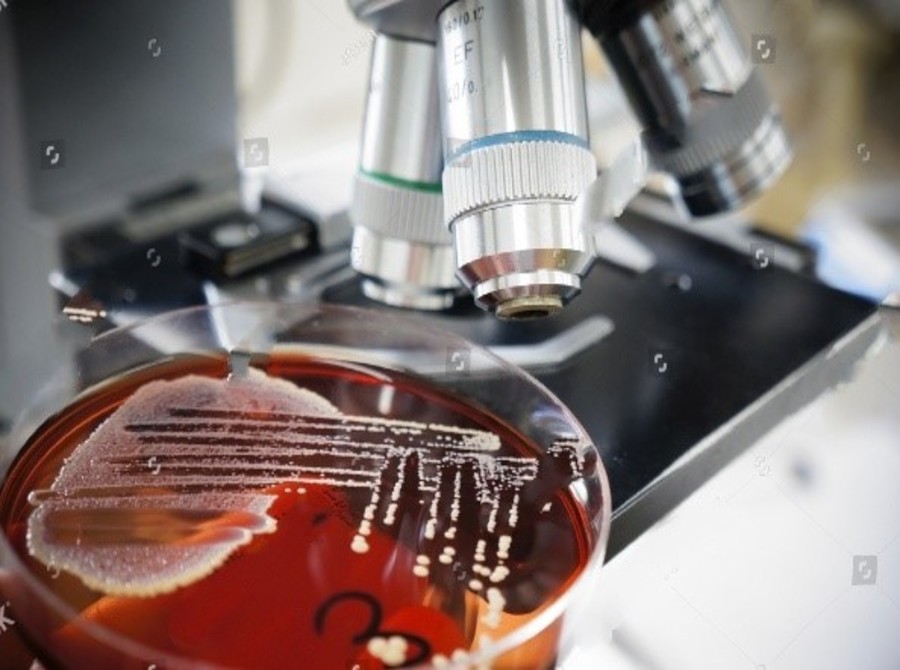

FREE HOME SAMPLE COLLECTION
(08:00AM-9:00PM)
HOME SAMPLINGSAHULAT Specimen Home Collection
Introducing the convenience of collection medical specimen from your door step. Ideal for busy professionals, school going children and especially elderly patients. No need to wait in queue or leave your comfort zone. We are only a phone call away or you may text us or for an instant response. Your reports are promptly delivered to you by whatsapp as well as on your provided email address.
WE ARE JUST APHONE CALL AWAY


We ensure that you always get the best result.State of the art technology











Certifications